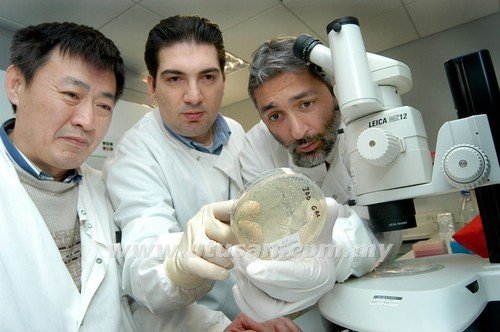

PERANAN PRINSIP ETIKA
Rujukan kepada saintis , teknokrat dalam melakukan penyelidikan dan penghasilan perkara-perkara yang baru.
Menjaga batasan dan memantau perkara-perkara yang boleh dilakukan oleh saintis , teknokrat dan jurutera dalam penyelidikan masing-masing. Apa jua kerja yang dilakukan hendaklah selaras dengan roh dan maksud syariat dan etika islam.
Sains juga tidak terlepas dari syariat dan ketetapan hukum yang asasi bagi memastikan kerja-kerja yang dilakukan menepati kehendak syariat.

Mejaga kepentingan umum dari ketamakan dan kerakusan para saintis, teknokrat dan jurutera yang mengancam keselamtan manusia
Melahirkan saintis , teknokrat dan jurutera yang berdisiplin tinggi, beradab dan mengerti peranan manusia sebagai khalifah di bumi.
Menetukan dasar dalam aktiviti sains, teknologi dan kejuruteraan agar benar pada matlamatnya.